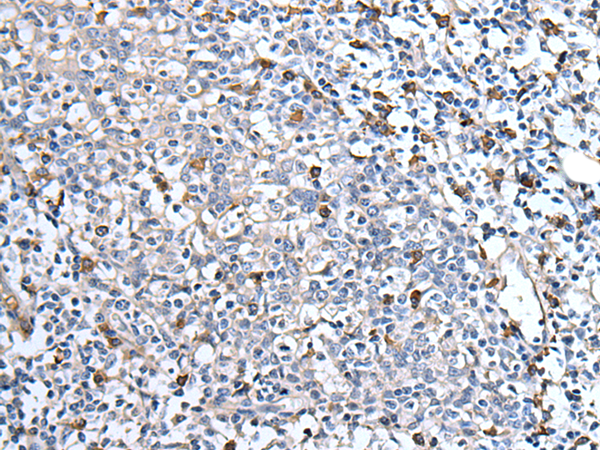
Rabbit Polyclonal Antibody to MEN1

提醒成功

搜索
Rabbit Polyclonal Antibody to MEN1
-
货号:
P12718 -
别名:
MEAI; SCG2 -
应用:
WB,IHC -
反应种属:
Human, Mouse, Rat -
抗体类型:
Primary antibody -
Swissprot:
O00255 -
规格:
-
数量:
-+ -
说明书:
目录价¥1980

Rabbit Polyclonal Antibody to MEN1
Description |
|---|
This gene encodes menin, a putative tumor suppressor associated with a syndrome known as multiple endocrine neoplasia type 1. In vitro studies have shown menin is localized to the nucleus, possesses two functional nuclear localization signals, and inhibits transcriptional activation by JunD, however, the function of this protein is not known. Two messages have been detected on northern blots but the larger message has not been characterized. Alternative splicing results in multiple transcript variants. |
Specification |
|
|---|---|
| Aliases | MEAI; SCG2 |
| Swissprot | O00255 |
| WB Predicted band size | 68 kDa |
| Host/Isotype | Rabbit IgG |
| Antibody Type | Primary antibody |
| Storage | Store at 4°C short term. Aliquot and store at -20°C long term. Avoid freeze/thaw cycles. |
| Species Reactivity | Human, Mouse, Rat |
| Immunogen | Synthetic peptide of human MEN1 |
| Formulation | Purified antibody in PBS with 0.05% sodium azide and 50% glycerol. |
Application |
|
|---|---|
| WB | 1/500-1/2000 |
| IHC | 1/25-1/100 |
| ELISA | 1/5000-1/10000 |
Product Image
- Gel: 6%SDS-PAGE, Lysate: 40 μg, Lane 1-2: Raji and Jurkat cell lysates, Primary antibody: P12718(MEN1 Antibody) at dilution 1/400, Secondary antibody: Goat anti rabbit IgG at 1/8000 dilution, Exposure time: 10 seconds
- The image is immunohistochemistry of paraffin-embedded Human tonsil tissue using P12718(MEN1 Antibody) at dilution 1/40. (Original magnification: ×200)
For Reseach Only
Application Key:WB - Western Blot | IHC - Immunohistochemistry | ICC - Immunocytochemistry | FCM - Flow Cytometry | ELISA - Enzyme-linked Immunosorbent Assay | IP - Immunoprecipitation
#P12718

相关产品















 微信/QQ登录
微信/QQ登录


 首页
首页